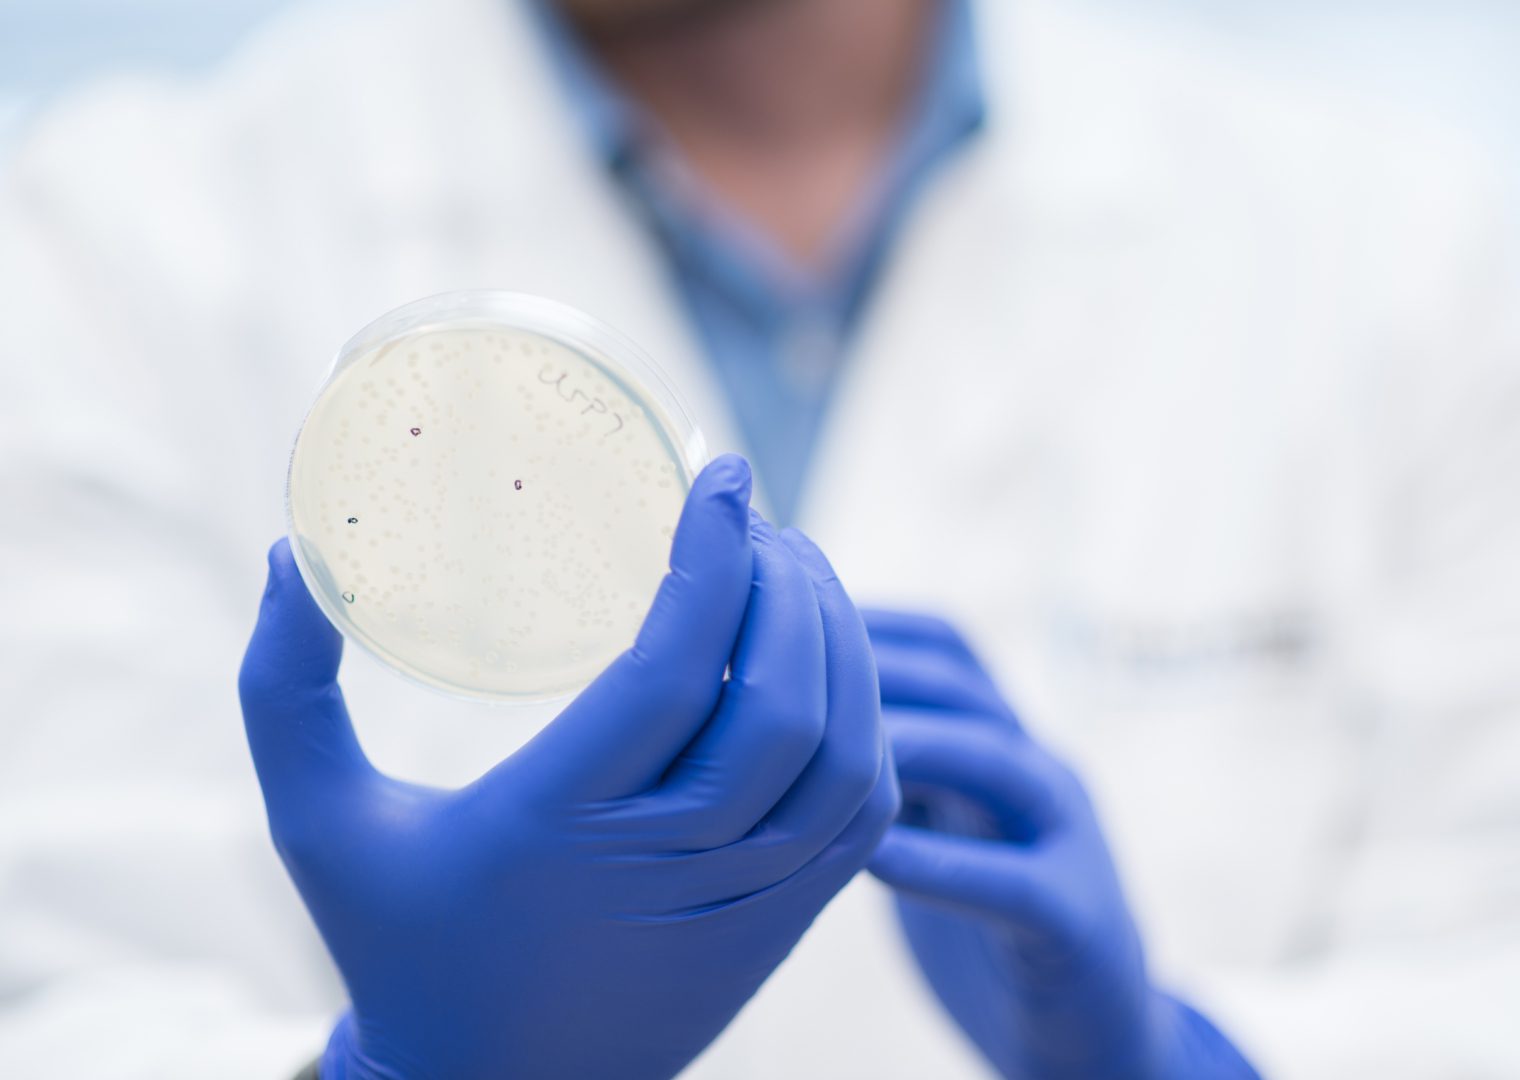

Collaborations
Focal Centers
Hubs for clinical translation
Van Andel Institute’s Focal Centers in cancer and Parkinson’s are hubs for translating groundbreaking discoveries into clinical trials. Established in 2020, the VAI Cancer Center and VAI Parkinson’s Disease Center provide support and infrastructure for scientists to develop and implement translational cancer and Parkinson’s disease projects in Grand Rapids and beyond, both in the lab and clinic. In the coming years, we expect the number of projects supported by the Centers to grow, multiplying the Institute’s impact in cancer and Parkinson’s — diseases that affect millions of people around the world.
Cancer Center
The Cancer Center supports projects and clinical trials in several different types of cancer in partnership with organizations in the U.S. and abroad.
Learn MoreParkinson's Disease Center
The goal of the Parkinson’s Disease Center is to support projects and clinical trials that investigate potential therapies to slow or stop Parkinson’s progression — a feat not possible with existing treatments.
Learn MoreCollaborations
Van Andel Institute–Stand Up To Cancer Epigenetics Dream Team
Finding the cancer therapies of tomorrow requires visionary thinking and innovative research today. The Van Andel Institute–Stand Up To Cancer Epigenetics Dream Team fosters collaboration between several of the world’s most respected research and clinical organizations in an effort to quickly move promising potential therapies into clinical trials.
Learn MoreInternational Linked Clinical Trials
Since 2012, VAI has partnered with Cure Parkinson’s to support clinical trials of medications developed to treat other diseases that also show potential for impeding Parkinson’s progression.
Learn MoreEpigenetic Therapies SPORE Collaboration
The Epigenetics Therapies SPORE (Specialized Program of Research Excellence) is a National Cancer Institute-funded collaboration of nearly 20 scientists who seek to improve cancer therapies.
Learn MoreWest Michigan Neurodegenerative Diseases (MiND) Program
The MiND Program is home to collaborative sample collection and genetic sequencing efforts. The data from this work will be used to identify genetic changes that may play roles in diseases such as Parkinson’s and dementias.
Learn MoreMetabolism and Nutrition (MeNu) Program
The MeNu Program seeks to rapidly expand VAI’s metabolism research capabilities, giving our scientists the tools they need to investigate metabolism in health and disease.
Learn More